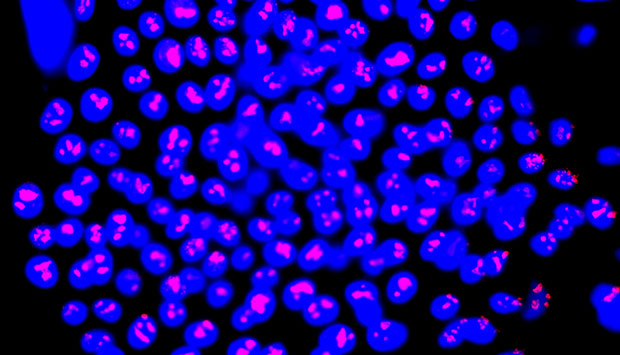

ATP-binding-cassette G2 (ABCG2)-positive skin cells (blue) show positive staining of cell proliferation marker Ki-67 (red), which marks cells with the most growth potential.
© 2016 Dongrui Ma, Singapore General Hospital
Better treatment for burn victims could follow the discovery of a new marker that can selectively isolate stem cells from a skin sample. This technique, developed by a Singaporean research collaboration, could produce more robust, higher-quality grafts for patients who sustain severe burns, potentially improving treatment for more than 11 million people worldwide each year.
Transplanted skin grafts are used to temporarily cover the large burnt regions of patients’ bodies, protecting them from infection and dehydration. This buys time for doctors to ‘culture’ the patients’ own skin cells in the lab, growing cultured grafts that can permanently replace the donor skin. Pioneered by physician Howard Green in the 1970s, this technique has greatly reduced burn-related mortality.
“Since Howard Green, there has been no technology for skin replacement that surpasses cultured skin grafts,” says Alvin Chua from the Burns Unit at Singapore General Hospital.
To build an improved cultured skin graft, a team led by doctors from Singapore General Hospital and including research colleagues at A*STAR looked to optimize the cell culture step.
“Cultured grafts are usually very fragile,” says Birgit Lane from the A*STAR Institute of Medical Biology. Researchers sought to ‘enrich’ and fortify the grafts by including more stem cells, a cell type with potent tissue repair capability. They needed a cellular marker to identify skin stem cells: a protein usually tasked with evicting foreign chemicals from cells, ATP-binding-cassette G2 (ABCG2), fitted the bill.
Promisingly, “ABCG2 is a cell-surface marker, so we can isolate live cells using a cell-sorting technology,” says Dongrui Ma, the paper’s lead author. Often, stem cell markers cannot target live cells, which limits their clinical applications.
Next they tested human cultured skin, grafted on to mice lacking immune function. ABCG2-positive cultured cells formed thicker and healthier grafts than mixed ABCG2-positive and -negative cells. By contrast, grafts created from ABCG2-negative cells were thin, fragile, and failed to form a healthy outer skin layer.
Excitingly, the results also hinted that ABCG2 identifies skin pigmentation stem cells, called melanocytes. “If this molecule can also isolate the melanocyte stem cells, it would be very useful,” says Ma, as melanocytes are usually destroyed by deep burns. Restoring them could facilitate a graft that blends better with the patient’s existing skin.
Chua sees great promise for cultured stem cell application in the clinic, but warns that cost could be a barrier to widespread use. He hopes that future research will further improve graft quality, while also speeding production and saving cost. “For severe burn patients, time is of the essence.”
The A*STAR-affiliated researchers contributing to this research are from the Institute of Medical Biology. For more information about the team’s research, please visit the Epithelial Biology Group webpage.